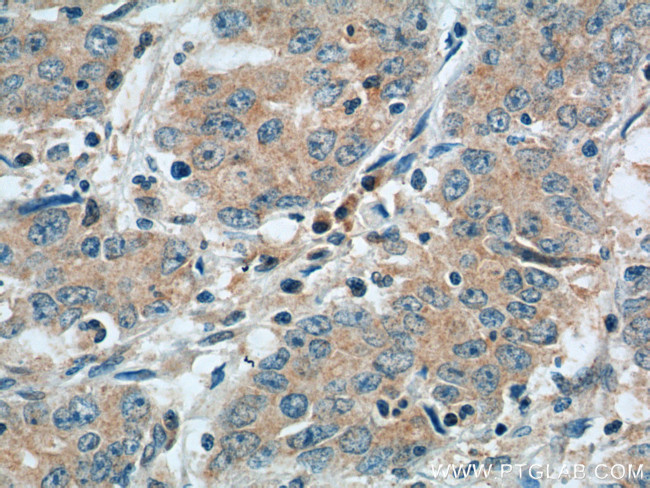
NPR1 Antibody in Immunohistochemistry (Paraffin) (IHC (P))

Search
Proteintech
NPR1 Polyclonal Antibody
{{$productOrderCtrl.translations['antibody.pdp.commerceCard.promotion.promotions']}}
{{$productOrderCtrl.translations['antibody.pdp.commerceCard.promotion.viewpromo']}}
{{$productOrderCtrl.translations['antibody.pdp.commerceCard.promotion.promocode']}}: {{promo.promoCode}} {{promo.promoTitle}} {{promo.promoDescription}}. {{$productOrderCtrl.translations['antibody.pdp.commerceCard.promotion.learnmore']}}
产品信息
55116-1-AP
种属反应
已发表种属
宿主/亚型
分类
类型
抗原
偶联物
形式
浓度
规格
纯化类型
保存液
内含物
保存条件
运输条件
靶标信息
Guanylyl cyclases, catalyzing the production of cGMP from GTP, are classified as soluble and membrane forms. The membrane guanylyl cyclases, often termed guanylyl cyclases A through F, form a family of cell-surface receptors with a similar topographic structure: an extracellular ligand-binding domain, a single membrane-spanning domain, and an intracellular region that contains a protein kinase-like domain and a cyclase catalytic domain. GC-A and GC-B function as receptors for natriuretic peptides; they are also referred to as atrial natriuretic peptide receptor A and type B. Also see NPR3, which encodes a protein with only the ligand-binding transmembrane and 37-amino acid cytoplasmic domains. NPR1 is a membrane-bound guanylate cyclase that serves as the receptor for both atrial and brain natriuretic peptides and BNP, respectively).
仅用于科研。不用于诊断过程。未经明确授权不得转售。
生物信息学
蛋白别名: ANP-A; ANPR-A; ARABIDOPSIS NONEXPRESSER OF PR GENES 1; AT1G64280; ATNPR1; Atrial natriuretic peptide receptor 1; atrial natriuretic peptide receptor guanylate cyclase; Atrial natriuretic peptide receptor type A; atrionatriuretic peptide receptor A; F15H21.6; F15H21_6; GC-A; Guanylate cyclase A; natriuretic peptide A type receptor; natriuretic peptide receptor A; natriuretic peptide receptor A/guanylate cyclase A (atrionatriuretic peptide receptor A); NIM1; NON-INDUCIBLE IMMUNITY 1; NONEXPRESSER OF PR GENES 1; NPR-A; REGULATORY PROTEIN NPR1; SAI1; SALICYLIC ACID INSENSITIVE 1; testicular tissue protein Li 20; unnamed protein product
基因别名: ANPa; ANPRA; GUC2A; GUCY2A; NPR1; NPRA
UniProt ID: (Human) P16066
Entrez Gene ID: (Human) 4881